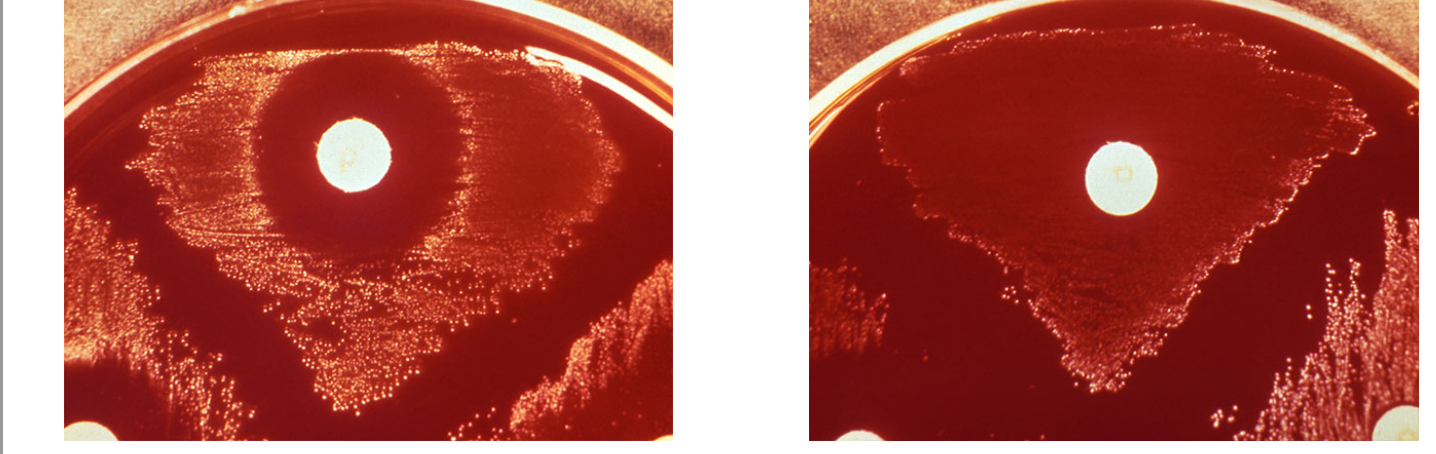
<p><span><span>After incubation with an optochin disc, you observe the plate results. Your plate is shown at the left with a control plate on the right. What can you conclude?</span></span></p>

microbio lab Q5
1/17
There's no tags or description
Looks like no tags are added yet.
Name | Mastery | Learn | Test | Matching | Spaced |
|---|
No study sessions yet.
18 Terms
coccus
Bacterial cell shape that is spherical or rounded in appearance.
gram stain
A differential stain for bacteria, useful in identification and taxonomy
morphology
the study and characterization of bacterial cells based on the microscopic form, arrangement, and structures of the microorganism.
staphylococcus
Round-shaped bacterial cells arranged in irregular clusters
streptococcus
Round-shaped bacterial cells arranged in chains.

gram negative bacilli
Your Gram stain is complete and correct. Which of the following statements would apply to the image you see?

unknown is negative, as S.aureus is known positive, so it can be ruled out
One initial suspect bacteria you considered was the common sepsis (bloodstream infection) organism Staphylococcus aureus. Why can we rule this organism out as the cause in the patient?

unknown is positive
The oxidase test is used to classify bacteria based on the presence or absence of cytochrome oxidase enzyme in an unknown organism. Here are the results of your oxidase test. What can you conclude?

extended incubation can lead to reversion and inconclusive results
Why is it important to observe and record results of your phenol red broth (PRB) immediately after 24 hours of incubation?
unknown is negative for glucose fermentation
The Phenol Red broth (PRB) test detects glucose fermentation in acidic products and is used to classify bacteria based on this result for an unknown organism. Here are the results of your PRB test. The broth on the left is your sample, compared to a control reaction on the right. Durham tubes can be disregarded, as no gas production is noted. What can you conclude?

no, incomplete bc unknown may reduce nitrate to other nitrogenous forms
After addition of nitrate reagents A and B, your tube remains colorless. Is your testing for nitrate complete?

colorless shows reduced nitrate to nitrogenous forms other than nitrite/nitrite reducer
After addition of nitrate reagents A and B, as well as zinc addition, your tube remains colorless. What can you conclude?

gram staining
Now that a pure culture has been isolated for you, what would be a good starting procedure to begin classifying your unknown organism?
gram positive cocci
Your Gram stain is complete and correct. Which of the following would apply to the image you see?

gram stain is positive, suggests streptococci. H influenzae is gram neg/ruled out
One initial suspect bacteria you considered was the common otitis media bacterium Haemophilus influenzae. Why can we rule this organism out as the cause in the patient?

catalase test is negative
The catalase test is used to classify bacteria based on the presence or absence of catalase enzyme in an unknown organism. Here are the results of your catalase test. What can you conclude?

blood agar hemolysis shows growth and alpha hemolytic
The blood agar hemolysis test grows bacteria with fastidious conditions and also differentiates between bacterial hemolysis of RBCs by visualization. Here are the results of your blood agar hemolysis test. What can you conclude?

zone of inhibition, sensitive to optochin
After incubation with an optochin disc, you observe the plate results. Your plate is shown at the left with a control plate on the right. What can you conclude?